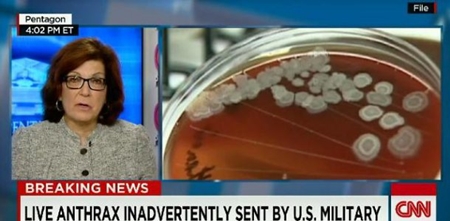

탄저균
[스포츠서울] 미 국방부가 살아있는 탄저균을 주한미군 오산기지로 잘못 배송해 논란인 가운데 그에 대한 정부의 입장이 눈길을 끌고 있다.
지난 16일 외교부 노광일 대변인은 이날 오후 서울 종로구 외교부 청사에서 "지난 10일 외교부 북미국장 주최로 주한미군 탄저균 배달사고 관련 관계 부처 합동회의가 개최됐다"고 밝혔다.
노 대변인은 "회의에 참석한 모든 부처와 기관들은 미측과 긴밀한 협의와 협조를 계속하는 가운데 SOFA(주한미군지위협정) 운영 절차 개선과 한·미 군당국 간 협력 강화 등을 포함한 재발 방지 대책을 모색하기로 입장을 정했다"고 회의의 결과를 소개했다.
이어 노 대변인은 "재발방지를 위해 SOFA 개정이 필요한지에 대한 여부는 좀 더 검토가 필요할 것 같다"며 "SOFA 개정 절차는 상당히 시간이 오래 소요되므로 그것보다는 운영 및 절차를 개선해 현실적으로 재발방지ㅠ대책을 마련하는 게 보다 더 현실적이지 않을까 하는 게 참가한 관계ㅠ부처와 기관들의 의견"이라고 전했다.
이를 본 네티즌들은 "탄저균, 이것도 심각한 문제지", "탄저균, 어떻게 되나", "탄저균, 무서워서 아무 데도 못 가겠다", "탄저균, 생물학 무긴데 당연히 걱정되지", "탄저균, 얼른 해결돼야 할 텐데" 등의 반응을 보였다.
한편, 탄저균은 치사율이 80~95%에 이르는 무서운 생물학 무기로 이 균에 노출돼 탄저병에 걸리면 대부분 죽는 것으로 알려졌다. 탄저균 100kg을 공중에 살포하면 300만 명까지 죽일 수 있을 정도로 엄청난 살상력을 가지고 있다.
김수현 인턴기자 news@sportsseoul.com
사진=CNN 방송화면 캡처
기사추천
0